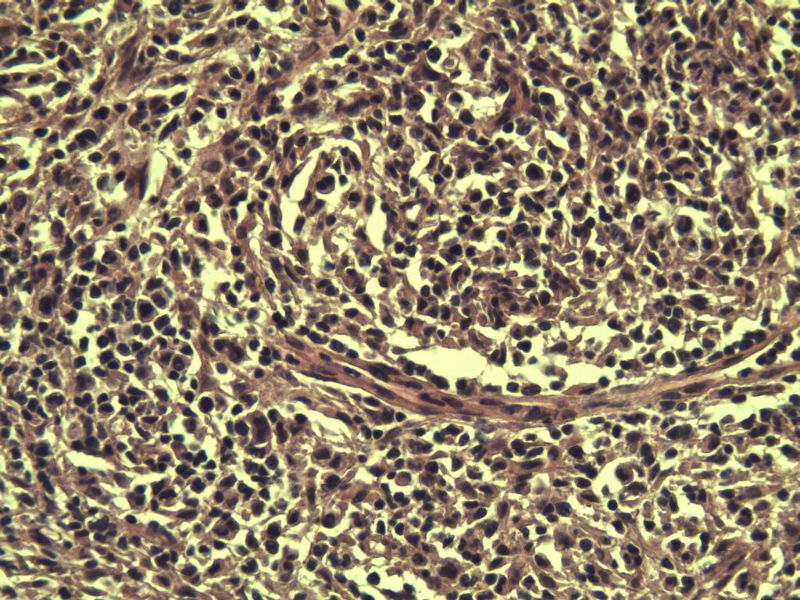
腹股沟 多枚淋巴结活检图8
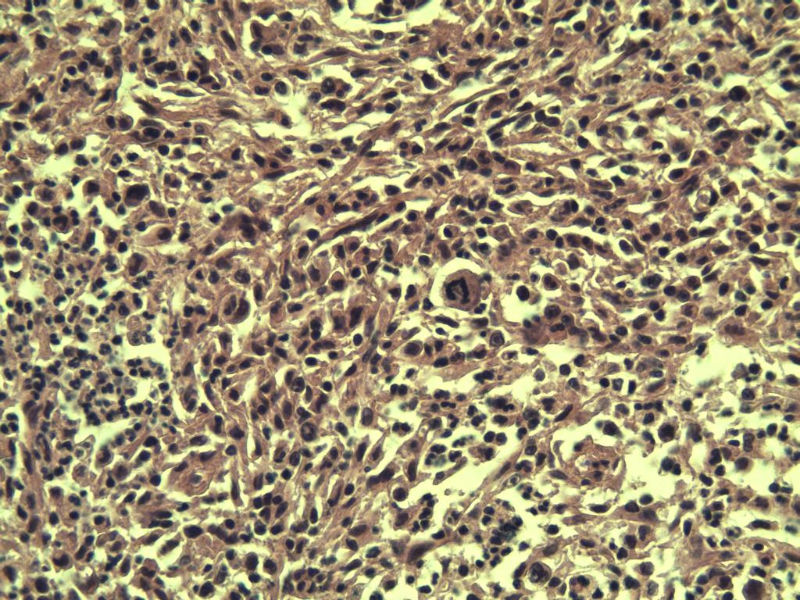
腹股沟 多枚淋巴结活检图9
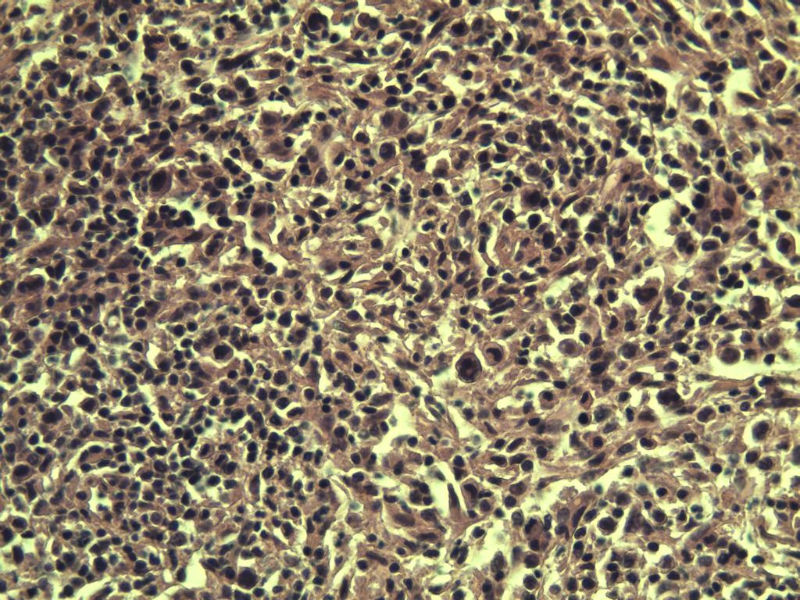
腹股沟 多枚淋巴结活检图10
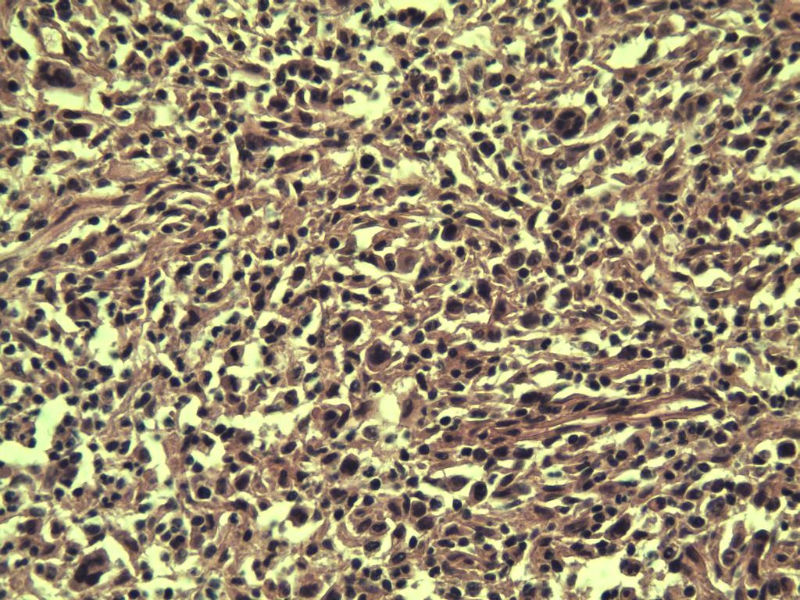
腹股沟 多枚淋巴结活检图11
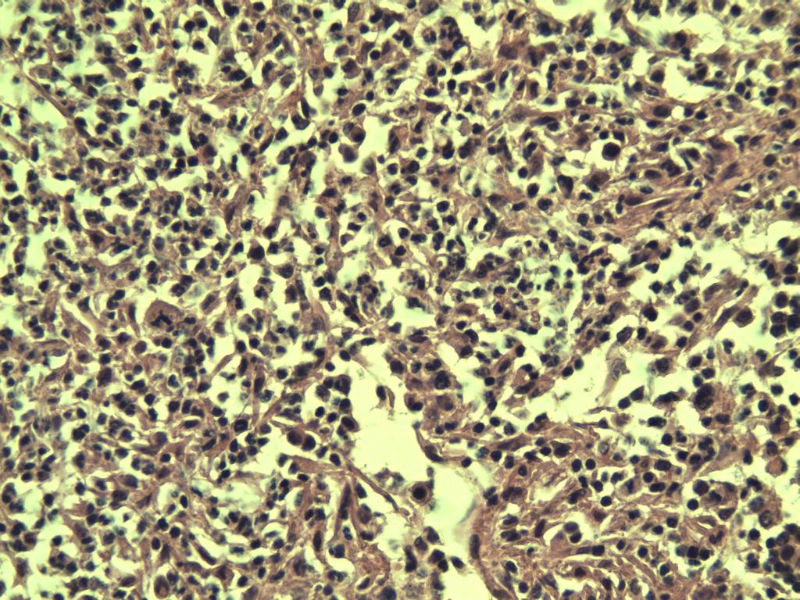
腹股沟 多枚淋巴结活检图13

| 图片: | |
|---|---|
| 名称: | |
| 描述: | |
- 腹股沟 多枚淋巴结活检
男,38岁,腹股沟 多枚淋巴结活检 直径 0.2-0.5 请各位老师看看 是什么 谢谢了!
"畏寒,发热咳嗽1年,加重伴腹部疼痛2月" 2月前患者感腹部疼痛不适伴大便呈稀大便,量不详,伴腰骶部疼痛,胸片:纵膈及右肺门多发性淋巴结肿大,进一步完善胸部CT:右肺及中叶病变,纵膈及肺门多发淋巴结肿大,结核性可能,脾脏增大,PPD(-),1个月来患者出现中上腹食欲不振,体重进行性消瘦,全身疲乏无力,3天前到医学院就诊,腹部B超:右肝囊肿,胆囊壁毛糙,脾大,胰周多个减弱回声,淋巴结不能除外,腹水,血常规示:WBC16.36x109 /L,N%14.25%,RBC2.63x1012/L ,HGB 66g/L 。右侧腋窝及腹股沟可扪及多枚淋巴结,压痛,无明显粘连。

名称:图1
描述:a2.Jpg.jpg

名称:图2
描述:a3.Jpg.jpg

名称:图3
描述:a4.Jpg.jpg

名称:图4
描述:a5.Jpg.jpg

名称:图5
描述:a6.Jpg.jpg

名称:图6
描述:a7.Jpg.jpg

名称:图7
描述:a8.Jpg.jpg
名称:图8
描述:a9.Jpg.jpg
名称:图9
描述:a10.Jpg.jpg
名称:图10
描述:a11.Jpg.jpg
名称:图11
描述:a12.Jpg.jpg

名称:图12
描述:a13.Jpg.jpg
名称:图13
描述:a14.Jpg.jpg

名称:图14
描述:a15.Jpg.jpg

名称:图15
描述:a16.Jpg.jpg

名称:图16
描述:a17.Jpg.jpg
标签:
×参考诊断


















